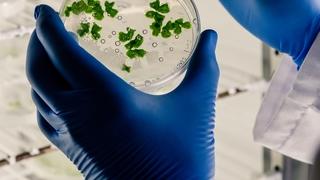

Le compromis reprend les grandes lignes de la position des États membres écartant la plupart des demandes portées par le Parlement européen : étiquetage tout au long de la chaîne alimentaire et interdiction des brevets. Les eurodéputés impliqués dans les pourparlers ont seulement réussi à imposer des critères de définition plus stricts. Le vote du Parlement, prévu autour du mois de mars, promet d’être serré, les groupes politiques étant très divisés sur le dossier.
Deux ans et demi après la proposition de la Commission...
Article réservé aux abonnés
Accédez à l'intégralité du site et recevez Le Sillon Belge toutes les semaines
Déjà abonné au journal ?
Se connecter ou Activez votre accès numérique










